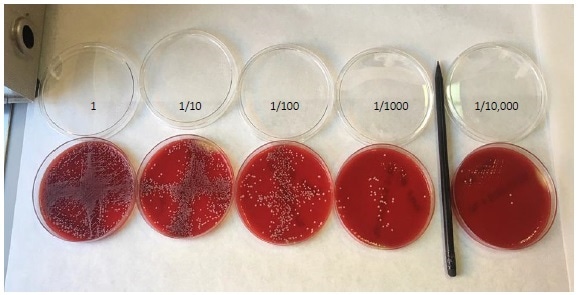
Colony counting on agar plates. A dilution series of C. albicansspiked into whole blood, plated and counted by eye.

Jul 12 2018
Candida species are fungal pathogens that can commonly cause infection. Candida albicans (C. albicans), for example, is commonly detected in the blood of post-operative and immunocompromised patients.
However, although tests have been developed to identify the presence of circulating Candida antigens for diagnosis of candida infection (candidiasis), testing in clinic continues to be predominantly based on culture-based methods rather than PCR-based molecular diagnosis.
Preparation and Extraction of DNA with ARCIS Technology
Recently, a solution to this issue has been presented by ARCIS-Biotechnology, who offer a rapid system for blood processing that allows extraction and stabilization of fungal genomic targets.
This happens within a rapid two-step process, whereby diluted blood samples are initially incubated with ARCIS stabilization reagent to protect from degradation of genomic contents, before being mixed a reagent enabling samples to be directly used with a PCR master mix for amplification and sequencing analysis.
Research using this procedure on clinical fungi specimens, such as C. albicans, has shown that all samples processed using the ARCIS system maintain stability, are compatible with PCR and qPCR, and can be correctly identified by Sanger or pyro sequencing analysis.

Figure 1. Rapid sample processing protocol. See ’Methods’ for further detail
Table 1. Sequencing analysis. All samples were processed rapidly and subjected to PCR and Pyrosequencing. All samples were PCR positive and correctly identified by sequencing analysis.


Figure 2. End point PCR results. A dilution series of C. albicansspiked into whole blood.
Figure 3. Colony counting on agar plates. A dilution series of C. albicansspiked into whole blood, plated and counted by eye.
In addition, further genomic analysis within a small cohort of clinical specimens that were prepared and extracted using the ARCIS system showed an analytical sensitivity of 6 colony-forming units per test which is equal to that required for microscopic analysis in blood culture.
Overall, the entire process of extraction and detection requires approximately three hours to complete. As typical molecular diagnostic techniques are highly complex and time consuming, the rapid sample preparation produced with this novel system significantly increases the applicability of such techniques in clinical settings.
Conclusion
Such evidence confirms that teaming ARCIS novel technology with a quantitative Polymerase Chain Reaction (qPCR) test could aid the development of specific, sensitive and rapid diagnosis of fungal infections caused by candida pathogens.
References
- Burgener-Kairuz P, Zuber J P, Jaunin P, Buchman T G, Bille J, Rossier M. Rapid detection and identification of Candida albicans and Torulopsis (Candida)glabrata in clinical specimens by species-specific nested PCR amplification of a cytochrome P-450 lanosterol-α-demethylase (L1A1) gene fragment. J Clin Microbiol. 1994;32:1902–1907.
- Burnie J P, Golbang N, Mathews R C. Semiquantitative polymerase chain reaction enzyme immunoassay for diagnosis of disseminated candidiasis. Eur J Clin Microbiol Infect Dis. 1997;16:346–350.
- Chryssanthou E, Anderson B, Petrint B, Lofdahl S, Tollemar J. Detection of Candida albicans DNA in serum by polymerase chain reaction. Scand J Infect Dis. 1994;26:479–485.
 About Arcis Biotechnology
About Arcis Biotechnology
Arcis Biotechnology is a research and development led company with expertise in the development and commercialization of a wide range of fast and convenient sample preparation technologies.
Based at Sci-tech Daresbury, where we have fully equipped laboratory facilities, the Group has already developed a number of patented compounds and technologies that have been enthusiastically received in the commercial marketplace via our licensing partners.
Arcis Biotechnology is focused on providing fast and convenient nucleic acid sample preparation solutions. Obtaining genetic material from biological samples is a critical step in molecular biology processes which is often time consuming and inefficient.
In less than 3 minutes with no prior sample preparation the Arcis Sample Prep range of products allow users to quickly and conveniently go from biological material to downstream nucleic acid investigation using PCR, qPCR, RT-qPCR or sequencing without the need for traditional isolation or purification.
Arcis DNA Isolation Video
The process requires no laboratory equipment and requires as little as 30 µl of blood as a starting material. Arcis products can be used on many different samples containing DNA or RNA including whole blood, plasma, urine, buccal swabs, hair follicles and microbiological samples including bacteria (E. coli, S. aureus, P. aeruginosa, K. pneumonia), viruses (HBV/ HCV) and parasites (plasmodium).
Sponsored Content Policy: News-Medical.net publishes articles and related content that may be derived from sources where we have existing commercial relationships, provided such content adds value to the core editorial ethos of News-Medical.Net which is to educate and inform site visitors interested in medical research, science, medical devices and treatments.